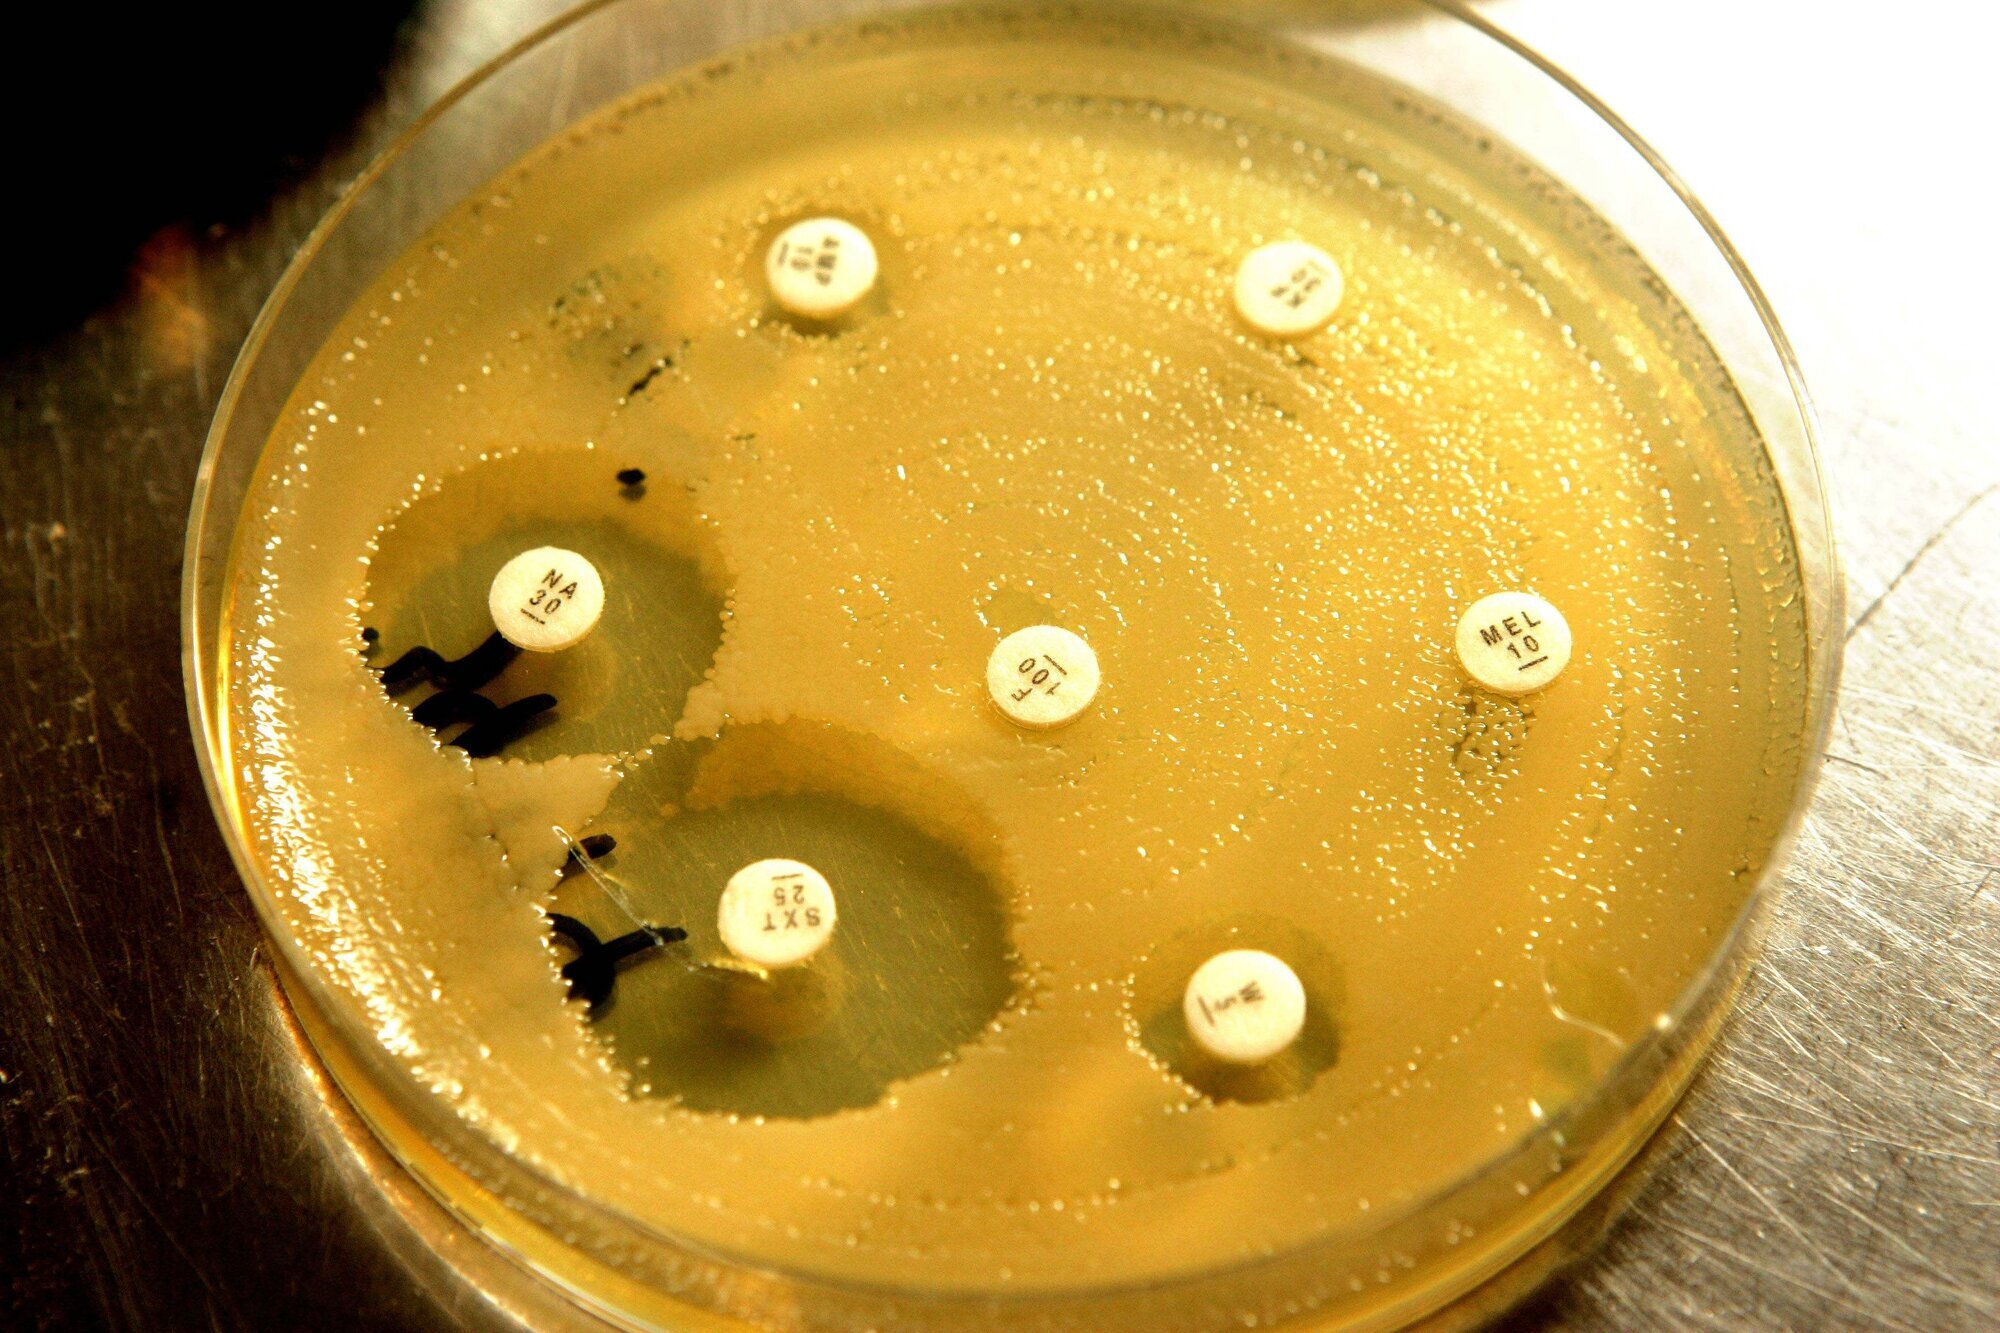
Bildet viser antibiotikaresistente bakterier i en petriskål

Overlege slår alarm om antibiotikaimport
Det er ikke trygt at Norge belager seg på import av antibiotika, sier overlege Dag Berild ved Ullevål sykehus. Han mener produksjonen må skje i Europa.
Produksjonen av antibiotika har vært så lite lønnsom at det meste blir importert fra land som Kina og India.
– Det setter oss i en usikker posisjon, både med tanke på stabil tilgang og kvalitet, sier Berild til Klassekampen. Han viser til faren ved at man ikke får tak i de «gamle» sortene antibiotika, fordi nyere typer, som er mer resistensdrivende, er mer lønnsomme.
Berild mener politikerne må begynne å se alvoret i situasjonen og ta grep for å sikre trygg produksjon av det antibiotikumet som trengs.
LES: Slik kan sykepleiere redusere antibiotikabruken
– Farlig for norske pasienter
Nestleder i helse- og omsorgskomiteen Kjersti Toppe (Sp) mener regjeringen har vært naiv når det forventes at legemiddelindustrien skal ta ansvar for en forsvarlig tilgang til livsnødvendige legemidler.
– Vi har til tider opplevd alvorlige mangler som har vært underkommunisert. Det vil være farlig for norske pasienter om dette ikke blir løftet opp politisk, sier hun.
Helsekomitémedlem Sveinung Stensland (H) mener på sin side det er naivt å tro at Norge kan være selvforsynt med antibiotika.
– Dette er et globalt problem som må bli løst internasjonalt, noe det også blir jobbet med, sier Stensland til Klassekampen.





















0 Kommentarer